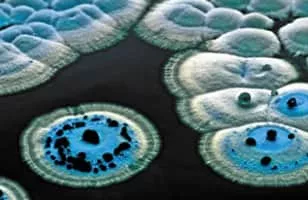

Streptomyces
| Use attributes for filter ! | |
| Family | Actinomycetaceae |
|---|---|
| Scientific name | Streptomyces |
| Class | Actinomycetes |
| Phylum | Actinobacteria |
| Rank | Genus |
| Did you know | Streptomycetes are characterised by a complex secondary metabolism. |
| Date of Reg. | |
| Date of Upd. | |
| ID | 1176264 |
About Streptomyces
Streptomyces is the largest genus of Actinobacteria and the type genus of the family Streptomycetaceae. Over 500 species of Streptomyces bacteria have been described. As with the other Actinobacteria, streptomycetes are gram-positive, and have genomes with high GC content.